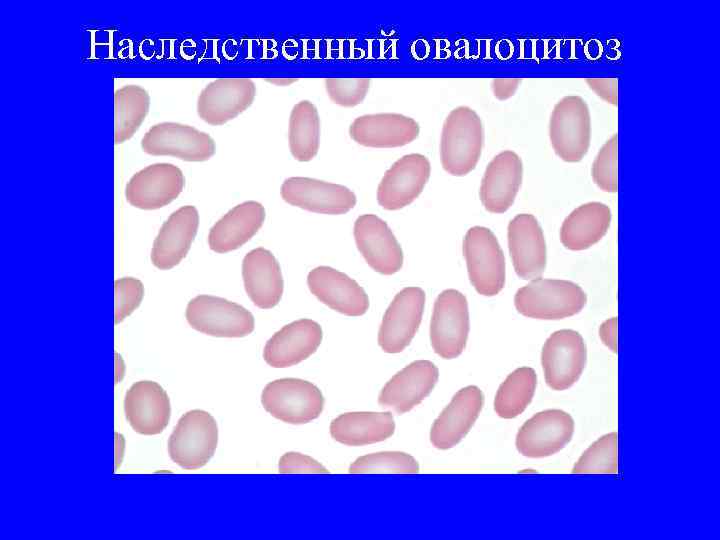
Наследственный овалоцитоз
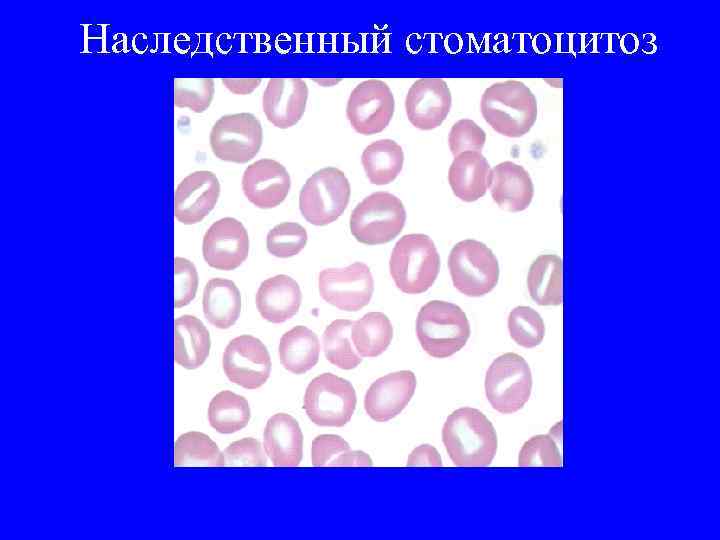
Наследственный стоматоцитоз
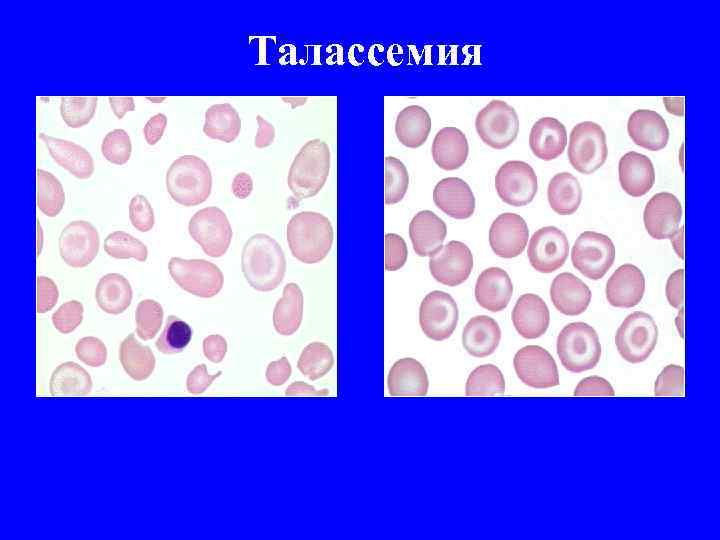
Талассемия
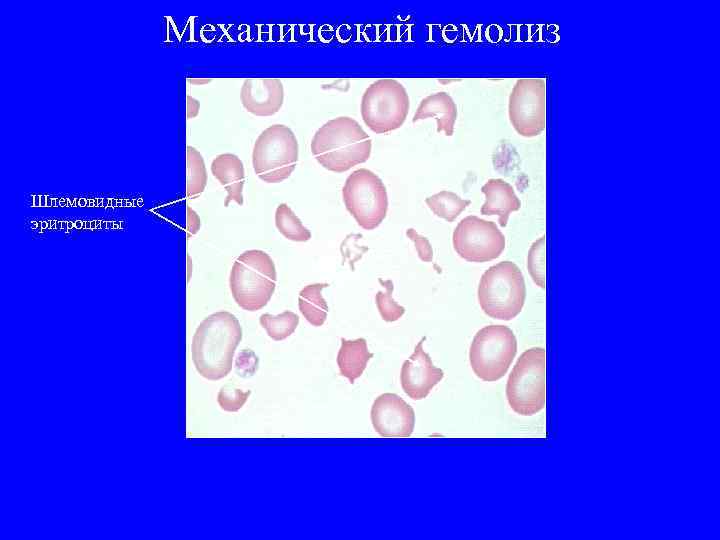
Механический гемолиз Шлемовидные эритроциты

ДИФФЕРЕНЦИАЛЬНАЯ ДИАГНОСТИКА АНЕМИЙ (ЧАСТЬ 2).ppt
- Количество слайдов: 79
 ДИФФЕРЕНЦИАЛЬНАЯ ДИАГНОСТИКА АНЕМИЙ (часть 2) Доцент кафедры госпитальной терапии Чернышева Е. Н
ДИФФЕРЕНЦИАЛЬНАЯ ДИАГНОСТИКА АНЕМИЙ (часть 2) Доцент кафедры госпитальной терапии Чернышева Е. Н
 ГЕМОЛИТИЧЕСКИЕ АНЕМИИ Гемолитические анемии (ГА) - это анемии, обусловленные усиленным разрушением эритроцитов - гемолизом. ГА различаются по механизму развития гемолиза, внутриклеточный или внутрисосудистый; течению заболевания: скорость развития анемии может варьировать от нескольких минут или часов, до нескольких дней, носить постоянный или рецидивирующий характер; методом диагностики и лечения.
ГЕМОЛИТИЧЕСКИЕ АНЕМИИ Гемолитические анемии (ГА) - это анемии, обусловленные усиленным разрушением эритроцитов - гемолизом. ГА различаются по механизму развития гемолиза, внутриклеточный или внутрисосудистый; течению заболевания: скорость развития анемии может варьировать от нескольких минут или часов, до нескольких дней, носить постоянный или рецидивирующий характер; методом диагностики и лечения.
 Клинически различают: • внутриклеточный гемолиз происходящий в клетках фагоцитарной системы (секвестральный гемолиз) • внутрисососудистый который возникает в сосудистом русле с участием комплемента (комплементарный гемолиз)
Клинически различают: • внутриклеточный гемолиз происходящий в клетках фагоцитарной системы (секвестральный гемолиз) • внутрисососудистый который возникает в сосудистом русле с участием комплемента (комплементарный гемолиз)
 Клинико – лабораторные проявления гемолитического синдрома • 1. Желтуха, не сопровождающаяся кожным зудом. Цвет кожи лимонно – желтый с одновременным наличием бледности.
Клинико – лабораторные проявления гемолитического синдрома • 1. Желтуха, не сопровождающаяся кожным зудом. Цвет кожи лимонно – желтый с одновременным наличием бледности.
 • 2. Нормохромная анемия (ЦП 0, 85 – 1, 05). Исключение составляют талласемии и эритропоэтическая протопорфирия (гипохромия). • 3. Выраженный ретикулоцитоз периферической крови. • 4. Раздражение эритроидного ростка в стернальном пунктате. • 5. Повышение содержания в крови неконъюгированного (непрямого) билирубина.
• 2. Нормохромная анемия (ЦП 0, 85 – 1, 05). Исключение составляют талласемии и эритропоэтическая протопорфирия (гипохромия). • 3. Выраженный ретикулоцитоз периферической крови. • 4. Раздражение эритроидного ростка в стернальном пунктате. • 5. Повышение содержания в крови неконъюгированного (непрямого) билирубина.
 • 6. Темный цвет мочи из-за уробилина. При пароксизмальной ночной гемоглобинурии и при пароксизмальной холодовой гемоглобинурии – в моче гемоглобин или гемосидери. • 7. Тёмный цвет кала за счет стеркобилина. • 8. Повышение содержания в крови свободного гемоглобина (при внутрисосудистом гемолизе). • 9. Увеличение селезенки (при внутриклеточном гемолизе).
• 6. Темный цвет мочи из-за уробилина. При пароксизмальной ночной гемоглобинурии и при пароксизмальной холодовой гемоглобинурии – в моче гемоглобин или гемосидери. • 7. Тёмный цвет кала за счет стеркобилина. • 8. Повышение содержания в крови свободного гемоглобина (при внутрисосудистом гемолизе). • 9. Увеличение селезенки (при внутриклеточном гемолизе).
 • 10. Укорочение длительности жизни эритроцитов - определяется с помощью пробы с радиоактивным хромом. • 11. Увеличение содержания железа в сыворотке крови • 12. Низкий уровень гаптоглобина в крови.
• 10. Укорочение длительности жизни эритроцитов - определяется с помощью пробы с радиоактивным хромом. • 11. Увеличение содержания железа в сыворотке крови • 12. Низкий уровень гаптоглобина в крови.
 К ГА с внутриклеточным механизмом гемолиза относятся: 1. наследственная мембранопатия эритроцитов (микросфероцитоз – болезнь Минковского. Шоффара, элиптоцитоз, стоматоцитоз, акантоцитоз); 2. врожденные ферментопатии эритроцитов (кроме дефицита Г-6 -ФД); 3. наследственная гемоглобинопатии (талассемии, серповидно-клеточные анемии); 4. иммунные ГА, кроме гемолизиновой формы аутоиммунной ГА; 5. анемии при гиперспленизме.
К ГА с внутриклеточным механизмом гемолиза относятся: 1. наследственная мембранопатия эритроцитов (микросфероцитоз – болезнь Минковского. Шоффара, элиптоцитоз, стоматоцитоз, акантоцитоз); 2. врожденные ферментопатии эритроцитов (кроме дефицита Г-6 -ФД); 3. наследственная гемоглобинопатии (талассемии, серповидно-клеточные анемии); 4. иммунные ГА, кроме гемолизиновой формы аутоиммунной ГА; 5. анемии при гиперспленизме.
 Внутриклеточный гемолиз Анемия Ретикулоциты Желтуха Нормохромная нормоцитарная (MCV=N, MCHC=N) Увеличена селезенка Более 1, 2% Гиперплазия эритроидного ростка костного мозга Повышен непрямой билирубин Увеличен стеркобилин кала Увеличены уробилиноиды мочи Увеличена печень
Внутриклеточный гемолиз Анемия Ретикулоциты Желтуха Нормохромная нормоцитарная (MCV=N, MCHC=N) Увеличена селезенка Более 1, 2% Гиперплазия эритроидного ростка костного мозга Повышен непрямой билирубин Увеличен стеркобилин кала Увеличены уробилиноиды мочи Увеличена печень
 К ГА с внутрисосудистым механизмом гемолиза относятся: 1. врожденная ГА, с дефицитом Г-6 -ФД (фавизм); 2. пароксизмальноя ночная гемоглобинурия болезнь Маркиафавы-Микели); 3. гемолизиновая форма аутоиммунной ГА; 4. приобретенные неиммунные ГА: микроангиопатические, обусловленные механическим повреждением эритроцитов при протезировании сосудов или клапанов сердца, стенозе аортального клапана, злокачественной гипертензии, ДВС-синдроме, гемолитикоуремическом синдроме, гемангиомах; токсические – при отравлении гемолитическими ядоми: уксусной кислотой, пчелиным, змеиным; при разрушении эритроцитов – паразитоми (малярия).
К ГА с внутрисосудистым механизмом гемолиза относятся: 1. врожденная ГА, с дефицитом Г-6 -ФД (фавизм); 2. пароксизмальноя ночная гемоглобинурия болезнь Маркиафавы-Микели); 3. гемолизиновая форма аутоиммунной ГА; 4. приобретенные неиммунные ГА: микроангиопатические, обусловленные механическим повреждением эритроцитов при протезировании сосудов или клапанов сердца, стенозе аортального клапана, злокачественной гипертензии, ДВС-синдроме, гемолитикоуремическом синдроме, гемангиомах; токсические – при отравлении гемолитическими ядоми: уксусной кислотой, пчелиным, змеиным; при разрушении эритроцитов – паразитоми (малярия).
 Внутрисосудистый гемолиз Анемия Нормохромная нормоцитарная (MCV=N, MCHC=N) Увеличена селезенка Ретикулоциты Более 1, 2% Гиперплазия эритроидного ростка костного мозга Гемоглобинурия Моча темно-красная, черная Белок значительно повышен Проба на кровь резко положительна В осадке эритроцитов нет, гемосидерин Более 3 мг/100 мл(ОБЫЧНО ОКОЛО 100 мг/100 мл) Свободный гемоглобин плазмы
Внутрисосудистый гемолиз Анемия Нормохромная нормоцитарная (MCV=N, MCHC=N) Увеличена селезенка Ретикулоциты Более 1, 2% Гиперплазия эритроидного ростка костного мозга Гемоглобинурия Моча темно-красная, черная Белок значительно повышен Проба на кровь резко положительна В осадке эритроцитов нет, гемосидерин Более 3 мг/100 мл(ОБЫЧНО ОКОЛО 100 мг/100 мл) Свободный гемоглобин плазмы
 В стернальном пунктате: резкая гиперплазия эритроидного ростка; на высоте гемолитического криза, если возникает относительная недо- статочность фолиевой кислоты, появляются признаки мегало бластического кроветворения.
В стернальном пунктате: резкая гиперплазия эритроидного ростка; на высоте гемолитического криза, если возникает относительная недо- статочность фолиевой кислоты, появляются признаки мегало бластического кроветворения.
 Костный мозг при гемолитической анемии
Костный мозг при гемолитической анемии
 Классификация гемолитических анемий I Наследственные гемолитические анемии 1. Мембранопатии- микросфероцитоз, овалоцитоз, стоматоцитоз. 2. Ферментопатии- связанные с нарушением активности ферментов в эритроцитах (Г-6 ФД, пируваткиназы, глютатионредуктазы и др) 3. Связанные с нарушением структуры или цепей глобина (талассемия, серповидноклеточная анемия, носительство аномального гемоглобина)
Классификация гемолитических анемий I Наследственные гемолитические анемии 1. Мембранопатии- микросфероцитоз, овалоцитоз, стоматоцитоз. 2. Ферментопатии- связанные с нарушением активности ферментов в эритроцитах (Г-6 ФД, пируваткиназы, глютатионредуктазы и др) 3. Связанные с нарушением структуры или цепей глобина (талассемия, серповидноклеточная анемия, носительство аномального гемоглобина)
 Классификация гемолитических анемий II Приобретенные ГА 1. Связанные с воздействием АТ к эритроцитам или эритроидным клеткам костного мозга 2. Связанные с изменениями структуры мембраны эритроцитов вследствие соматической мутации (б-нь Маркиафавы – Микели) 3. Связанные с механическими повреждениями оболочки эритроцитов (протезы клапанов сердца, маршевая гемоглобинурия)
Классификация гемолитических анемий II Приобретенные ГА 1. Связанные с воздействием АТ к эритроцитам или эритроидным клеткам костного мозга 2. Связанные с изменениями структуры мембраны эритроцитов вследствие соматической мутации (б-нь Маркиафавы – Микели) 3. Связанные с механическими повреждениями оболочки эритроцитов (протезы клапанов сердца, маршевая гемоглобинурия)
 Классификация гемолитических анемий II Приобретенные ГА (продолжение) 4. Обусловленные химическими повреждениями эритроцитов (гемолитические яды, тяжелые металлы, органические кислоты) 5. Связанные с недостатком витамина Е 6. Связанные с воздействием паразитов (малярия и др. )
Классификация гемолитических анемий II Приобретенные ГА (продолжение) 4. Обусловленные химическими повреждениями эритроцитов (гемолитические яды, тяжелые металлы, органические кислоты) 5. Связанные с недостатком витамина Е 6. Связанные с воздействием паразитов (малярия и др. )
 Виктор Михайлович Васнецов Структура мембраны эритроцитов Белки мембраны: Липиды мембраны: фосфолипиды (фосфотидилхолин - лецитин, фосфатидилэтаноламин, сфинголиелин, фосфатидилсерин) и свободный холестерин Интегральные: протеин 3 гликофорин Периферические: спектрин, актин, протеин ы (4, 2; 2, 1 и т. д. анкирин
Виктор Михайлович Васнецов Структура мембраны эритроцитов Белки мембраны: Липиды мембраны: фосфолипиды (фосфотидилхолин - лецитин, фосфатидилэтаноламин, сфинголиелин, фосфатидилсерин) и свободный холестерин Интегральные: протеин 3 гликофорин Периферические: спектрин, актин, протеин ы (4, 2; 2, 1 и т. д. анкирин
 Наследственные гемолитические анемии, обусловленные нарушением мембраны эритроцитов 1. Анемии обусловленные нарушением структуры белков мембраны - наследственный микросфероцитоз - наследственный стоматоцитоз, овалоцитоз - гемолитическая анемия, связанная с наследственным отсутствием Rh – антигенов и т. д. 2. Анемии обусловленные нарушением липидов мембраны - наследственный акантоцитоз, эхиноцитоз - наследственная гемолитическая анемия, обусловленная увеличением в мембране лецитина и т. д.
Наследственные гемолитические анемии, обусловленные нарушением мембраны эритроцитов 1. Анемии обусловленные нарушением структуры белков мембраны - наследственный микросфероцитоз - наследственный стоматоцитоз, овалоцитоз - гемолитическая анемия, связанная с наследственным отсутствием Rh – антигенов и т. д. 2. Анемии обусловленные нарушением липидов мембраны - наследственный акантоцитоз, эхиноцитоз - наследственная гемолитическая анемия, обусловленная увеличением в мембране лецитина и т. д.
 Болезнь Минковского - Шоффара • - частота встречаемости: 2 случая на 10000 населения в популяции; • - наследуется по аутосомно – доминантному типу • - описано немецким терапевтом Minkowsky (1900 г. ) и французским терапевтом Chauffard (1907 г. )
Болезнь Минковского - Шоффара • - частота встречаемости: 2 случая на 10000 населения в популяции; • - наследуется по аутосомно – доминантному типу • - описано немецким терапевтом Minkowsky (1900 г. ) и французским терапевтом Chauffard (1907 г. )
 Генетический дефект белков мембраны - спектрина, анкирина, протеинов 3 и 4. 2 Повышение проницаемости мембраны эритроцитов для Na и воды Микросфероцитоз эритроцитов, снижение осмотической стойкости Селезенка Фагоцитоз и гемолиз эритроцитов
Генетический дефект белков мембраны - спектрина, анкирина, протеинов 3 и 4. 2 Повышение проницаемости мембраны эритроцитов для Na и воды Микросфероцитоз эритроцитов, снижение осмотической стойкости Селезенка Фагоцитоз и гемолиз эритроцитов
 Анемия Гиперплазия красного кроветворного ростка костного мозга Гипоксия органов и тканей Усиленное образование и экскреция желчных пигментов Холелитиаз Повышение количества ретикулоцитов в периферической крови Темная моча (уробилинурия) Темный кал (повышенное содержание стеркобилина)
Анемия Гиперплазия красного кроветворного ростка костного мозга Гипоксия органов и тканей Усиленное образование и экскреция желчных пигментов Холелитиаз Повышение количества ретикулоцитов в периферической крови Темная моча (уробилинурия) Темный кал (повышенное содержание стеркобилина)
 Клиническая картина • 1. В период обострения жалобы: - общая слабость, утомляемость; - головокружение; - головные боли; - снижение аппетита; - боли в правом подреберье; - одышку при нагрузке; - желтуху
Клиническая картина • 1. В период обострения жалобы: - общая слабость, утомляемость; - головокружение; - головные боли; - снижение аппетита; - боли в правом подреберье; - одышку при нагрузке; - желтуху
 • 2. При осмотре: - «генетические стигмы» (высокое «готическое» небо, западение переносицы, зубные аномалии, «башенный череп» , синдактилия, полидактилия, микрофтальмия) - трофические язвы голеней ( из - за нарушения микроциркуляции под влиянием обломков эритроцитов); - симптоматика миокардиодистрофии (тахикардия, глухость сердечных тонов, негромкий систолический шум на верхушке); - болезненность при пальпации в правом подреберье (калькулёзный холецистит); - спленомегалия;
• 2. При осмотре: - «генетические стигмы» (высокое «готическое» небо, западение переносицы, зубные аномалии, «башенный череп» , синдактилия, полидактилия, микрофтальмия) - трофические язвы голеней ( из - за нарушения микроциркуляции под влиянием обломков эритроцитов); - симптоматика миокардиодистрофии (тахикардия, глухость сердечных тонов, негромкий систолический шум на верхушке); - болезненность при пальпации в правом подреберье (калькулёзный холецистит); - спленомегалия;
 Гемолитические кризы • - сильные боли в животе, преимущественно в области печени и правого подреберья • - тошнота, рвота • - головная боль • - появление судорог • - повышение температуры • - усиление бледности и желтушности кожи и видимых слизистых оболочек • - усиление тёмного цвета мочи • - увеличение печени и селезенки • - выраженный лейкоцитоз, ускоренное СОЭ
Гемолитические кризы • - сильные боли в животе, преимущественно в области печени и правого подреберья • - тошнота, рвота • - головная боль • - появление судорог • - повышение температуры • - усиление бледности и желтушности кожи и видимых слизистых оболочек • - усиление тёмного цвета мочи • - увеличение печени и селезенки • - выраженный лейкоцитоз, ускоренное СОЭ
 Лабораторные данные и инструментальные исследования • Общий анализ крови – нормохромная анемия, лейкоциты и тромбоциты в норме • Мазок крови – микросфероциты (4 – 6 мкм)
Лабораторные данные и инструментальные исследования • Общий анализ крови – нормохромная анемия, лейкоциты и тромбоциты в норме • Мазок крови – микросфероциты (4 – 6 мкм)
 • Осмотическая резистентность эритроцитов – снижена • Миелограмма – гиперплазия красного мозга • Продолжительность жизни эритроцитов – снижена • Анализ кала – высокое содержание стеркобилина • УЗИ ОБП – увеличение селезенки, камни в ЖП, на поздних этапах – увеличение печени
• Осмотическая резистентность эритроцитов – снижена • Миелограмма – гиперплазия красного мозга • Продолжительность жизни эритроцитов – снижена • Анализ кала – высокое содержание стеркобилина • УЗИ ОБП – увеличение селезенки, камни в ЖП, на поздних этапах – увеличение печени
 • Общий анализ мочи – уробилинурия; при кризе - альбуминурия, макрогематурия • Биохимический анализ крови – повышено содержание билирубина за счёт неконъюгированного; при кризе – увеличение уровня АЛТ, АСТ, сывороточного железа
• Общий анализ мочи – уробилинурия; при кризе - альбуминурия, макрогематурия • Биохимический анализ крови – повышено содержание билирубина за счёт неконъюгированного; при кризе – увеличение уровня АЛТ, АСТ, сывороточного железа
 Диагностические критерии наследственного микросфероцитоза 1. Клиническая триада - гемолитическая желтуха (без кожного зуда) - спленомегалия - анемия (нормохромная) 2. Гематологическая триада - ретикулоцитоз - микросфероцитоз - снижение осмотической резистентности эритроцитов
Диагностические критерии наследственного микросфероцитоза 1. Клиническая триада - гемолитическая желтуха (без кожного зуда) - спленомегалия - анемия (нормохромная) 2. Гематологическая триада - ретикулоцитоз - микросфероцитоз - снижение осмотической резистентности эритроцитов
 3. Гиперплазия красного кроветворного ростка (миелограмма). 4. Повышение содержания железа в крови 5. Генетические стигмы. 6. Укорочение продолжительности жизни эритроцитов
3. Гиперплазия красного кроветворного ростка (миелограмма). 4. Повышение содержания железа в крови 5. Генетические стигмы. 6. Укорочение продолжительности жизни эритроцитов
 Лечение Наиболее эффективным методом лечения является спленэктомия. • Показания к спленэктомии: - выраженная анемия с клиническими проявлениями, гемолитическими кризами - осложнение заболевания желчной коликой и камнями в желчном пузыре - осложнение трофическими язвами голени - упорная желтуха
Лечение Наиболее эффективным методом лечения является спленэктомия. • Показания к спленэктомии: - выраженная анемия с клиническими проявлениями, гемолитическими кризами - осложнение заболевания желчной коликой и камнями в желчном пузыре - осложнение трофическими язвами голени - упорная желтуха
 Наследственный овалоцитоз Аутосомно – доминантная наследственная аномалия эритроцитов, связанная с нарушением структуры мембраны. Количество овалоцитов достигает 50 – 70% (в норме не более 10%). В большинстве случаев при овалоцитозе клинико – гематологические проявления отсутствуют. Диагноз устанавливается при просмотре мазков крови. Лечение при овалоцитозе без признаков гемолитической анемии не требуется. При наличии гемолитических кризов эффективна спленэктомия.
Наследственный овалоцитоз Аутосомно – доминантная наследственная аномалия эритроцитов, связанная с нарушением структуры мембраны. Количество овалоцитов достигает 50 – 70% (в норме не более 10%). В большинстве случаев при овалоцитозе клинико – гематологические проявления отсутствуют. Диагноз устанавливается при просмотре мазков крови. Лечение при овалоцитозе без признаков гемолитической анемии не требуется. При наличии гемолитических кризов эффективна спленэктомия.
Наследственный овалоцитоз
Наследственный овалоцитоз
Наследственный стоматоцитоз
Наследственный стоматоцитоз
 Акантоцитоз
Акантоцитоз
 Наследственные гемолитические анемии, связанные, с дефицитом ферментов эритроцитов (энзимопатии) Дефекты ферментов мембраны и цитоплазмы - дефицит Г 6 ФДГ (более 100 подтипов заболевания) – острые кризы - дефицит пируваткиназы - дефицит глютатионредуктазы
Наследственные гемолитические анемии, связанные, с дефицитом ферментов эритроцитов (энзимопатии) Дефекты ферментов мембраны и цитоплазмы - дефицит Г 6 ФДГ (более 100 подтипов заболевания) – острые кризы - дефицит пируваткиназы - дефицит глютатионредуктазы
 Энзимопенические ГА- группа заболеваний, характеризующиеся дефицитом активности эритроцитарных ферментов, чаще глюкозо- 6 - фосфатдегидрогеназы (Г- 6 -ГДФ) Классификация ВОЗ Варианты сопровождающиеся хронической гемолитической анемией: • 1. Варианты с уровнем активности фермента 0 -10% от нормы, носительство которых протекает без анемии вне криза и обусловливает развитие кризов приеме лекарств или употреблении конских бобов. • 2. Варианты с уровнем активности фермента 10 -60% при которых возникают редкие клинические проявления, связанные с приемом лекарств. • 3. Варианты с нормальным или близким к нормальному уровнем активности фермента в эритроцитах без клинических проявлений.
Энзимопенические ГА- группа заболеваний, характеризующиеся дефицитом активности эритроцитарных ферментов, чаще глюкозо- 6 - фосфатдегидрогеназы (Г- 6 -ГДФ) Классификация ВОЗ Варианты сопровождающиеся хронической гемолитической анемией: • 1. Варианты с уровнем активности фермента 0 -10% от нормы, носительство которых протекает без анемии вне криза и обусловливает развитие кризов приеме лекарств или употреблении конских бобов. • 2. Варианты с уровнем активности фермента 10 -60% при которых возникают редкие клинические проявления, связанные с приемом лекарств. • 3. Варианты с нормальным или близким к нормальному уровнем активности фермента в эритроцитах без клинических проявлений.
 ПАТОГЕНЕЗ Дефицит Г- 6 -ГДФ Нарушение образования АТФ и дефект системы глутатиона в эритроците Снижение способности эритроцитов противостоять свободнорадикальным соединениям Гемолиз эритроцитов (внутрисосудистый)
ПАТОГЕНЕЗ Дефицит Г- 6 -ГДФ Нарушение образования АТФ и дефект системы глутатиона в эритроците Снижение способности эритроцитов противостоять свободнорадикальным соединениям Гемолиз эритроцитов (внутрисосудистый)
 Факторы, вызывающие гемолиз 1. Противомалярийные препараты - хинин - делагил - примахин 2. Нестероидные противовоспалительные средства - ацетилсалициловая кислота - фенацетин 3. Антибактериальные средства -сульфаниламиды - нитрофураны - хлорамфеникол
Факторы, вызывающие гемолиз 1. Противомалярийные препараты - хинин - делагил - примахин 2. Нестероидные противовоспалительные средства - ацетилсалициловая кислота - фенацетин 3. Антибактериальные средства -сульфаниламиды - нитрофураны - хлорамфеникол
 4. Цитостатики - доксорубицин 5. Противотуберкулезные препараты - ПАСК - рифампицин 6. Антиаритмики - хинидин - новокаинамид 7. Употребление в пищу конских бобов (фавизм) 8. Инфекции - Острый гепатит - Инфекционный монокуклеоз - Сепсис 9. Диабетический кетоацидоз 10. Уремия
4. Цитостатики - доксорубицин 5. Противотуберкулезные препараты - ПАСК - рифампицин 6. Антиаритмики - хинидин - новокаинамид 7. Употребление в пищу конских бобов (фавизм) 8. Инфекции - Острый гепатит - Инфекционный монокуклеоз - Сепсис 9. Диабетический кетоацидоз 10. Уремия
 Клиническая картина В ремиссии клиники, как правило, нет, однако под влиянием интеркуррентных инфекций и после приема определенных препаратов окислителей (через 3 – 5 дней после приема!!!) может развиться острый внутрисосудистый гемолиз. - высокая температура - сильная головная боль - рвота с примесью желчи - выраженная желтуха -отсутствие спленомегалии - падение Hb и ретикулоцитов - моча темного цвета - резко увеличится неконъюгированный билирубин
Клиническая картина В ремиссии клиники, как правило, нет, однако под влиянием интеркуррентных инфекций и после приема определенных препаратов окислителей (через 3 – 5 дней после приема!!!) может развиться острый внутрисосудистый гемолиз. - высокая температура - сильная головная боль - рвота с примесью желчи - выраженная желтуха -отсутствие спленомегалии - падение Hb и ретикулоцитов - моча темного цвета - резко увеличится неконъюгированный билирубин

 Наследственные гемолитические анемии, связанные с нарушением структуры или синтеза гемоглобина (гемоглобинопатии) - Талассемии (количественные гемоглобинопатии) - Гемоглобинопатии (известно более 300 заболеваний, обусловленных точечными мутациями генов глобина) - Серповидноклеточная анемии (полимеризация Hb. S деформация эритроцита хронический гемолиз; - Hb. C, Hb. E, Hb. O и смешанные формы – синдром «серповидноклеточной анемии» (менее тяжелые)
Наследственные гемолитические анемии, связанные с нарушением структуры или синтеза гемоглобина (гемоглобинопатии) - Талассемии (количественные гемоглобинопатии) - Гемоглобинопатии (известно более 300 заболеваний, обусловленных точечными мутациями генов глобина) - Серповидноклеточная анемии (полимеризация Hb. S деформация эритроцита хронический гемолиз; - Hb. C, Hb. E, Hb. O и смешанные формы – синдром «серповидноклеточной анемии» (менее тяжелые)
 Талассемии -талассемия – дефект синтеза -цепи (отсутствует м. РНК в гене -цепи глобина). Выделено 4 гена в зависимости от нарушения, выделяют 4 типа (от бессимптомного течения до внутриутробной гибели плода); -талассемия – отсутствие или нарушение строения -цепи (м. РНК мало или дефектная). Выделяют 2 вида: - гомозиготная – большая талассемия, анемия Кули (тяжелое течение, больные трансфузионнозависимые); - гетерозиготная – малая талассемия (легкая форма, с редкими кризами) Диагностика: высокое содержание Hb. F и Hb. A 2
Талассемии -талассемия – дефект синтеза -цепи (отсутствует м. РНК в гене -цепи глобина). Выделено 4 гена в зависимости от нарушения, выделяют 4 типа (от бессимптомного течения до внутриутробной гибели плода); -талассемия – отсутствие или нарушение строения -цепи (м. РНК мало или дефектная). Выделяют 2 вида: - гомозиготная – большая талассемия, анемия Кули (тяжелое течение, больные трансфузионнозависимые); - гетерозиготная – малая талассемия (легкая форма, с редкими кризами) Диагностика: высокое содержание Hb. F и Hb. A 2
 При количественных гемоглобинопатиях (таласемиях) отмечается снижение синтеза определенной цепи глобина, приводящее к нарушению баланса количества различных цепей глобина, при этом структура цепей не нарушена. В крови больных талассемией обнаруживаются гипохромные мишеневидные эритроциты, повышено содержание Hb. F до 90% (в норме 0, 5 -2%) и Hb. A 2 более 3, 5% (при норме 1, 5 -3, 5%).
При количественных гемоглобинопатиях (таласемиях) отмечается снижение синтеза определенной цепи глобина, приводящее к нарушению баланса количества различных цепей глобина, при этом структура цепей не нарушена. В крови больных талассемией обнаруживаются гипохромные мишеневидные эритроциты, повышено содержание Hb. F до 90% (в норме 0, 5 -2%) и Hb. A 2 более 3, 5% (при норме 1, 5 -3, 5%).
 Диагностика ГА, обусловленных гемоглобинопатиями, основана: a) на исследовании эритроцитов в мазках крови при световой микроскопии и выявлении их характерных морфологических изменений; b) на выявлении аномальных форм Hb при его электрофоретическом исследовании.
Диагностика ГА, обусловленных гемоглобинопатиями, основана: a) на исследовании эритроцитов в мазках крови при световой микроскопии и выявлении их характерных морфологических изменений; b) на выявлении аномальных форм Hb при его электрофоретическом исследовании.
Талассемия
Талассемия
 Картина периферической крови при -талассемии RBC 4. 93 x 1012/л Hb 99 г/л MCV 63. 5 fl MCH 20. 3 пг MCHC 316 г/л RDW 18. 1 % смешанный анизоцитоз, гипохромия и мишеневидность эритроцитов
Картина периферической крови при -талассемии RBC 4. 93 x 1012/л Hb 99 г/л MCV 63. 5 fl MCH 20. 3 пг MCHC 316 г/л RDW 18. 1 % смешанный анизоцитоз, гипохромия и мишеневидность эритроцитов
 Гемоглобинопатии могут быть структурными, когда нарушается структура Hb – при серповидно -клеточной анемии вместо Hb. A в эритроцитах присутствует Hb. S, в котором в 6 положении βцепи глутаминовая кислота заменяется на валин. Это приводит к изменению свойств Hb. S имеет меньшую электрофоретическую подвижность, менее растворим, чем Hb. A. Выпадая в осадок и превращаясь в гель, он изменяет форму эритроцита. Серповидные эритроциты не могут проходить через капиллярное русло и разрушаются.
Гемоглобинопатии могут быть структурными, когда нарушается структура Hb – при серповидно -клеточной анемии вместо Hb. A в эритроцитах присутствует Hb. S, в котором в 6 положении βцепи глутаминовая кислота заменяется на валин. Это приводит к изменению свойств Hb. S имеет меньшую электрофоретическую подвижность, менее растворим, чем Hb. A. Выпадая в осадок и превращаясь в гель, он изменяет форму эритроцита. Серповидные эритроциты не могут проходить через капиллярное русло и разрушаются.
 Качественные гемоглобинопатии Серповидноклеточная анемия (Hb. S)
Качественные гемоглобинопатии Серповидноклеточная анемия (Hb. S)
 Лечение • Лечение серповидно-клеточной анемии симптоматическое - эффективных средств, подавляющих образование серповидных клеток in vivo, нет. • Гемотрансфузии могут привести к перегрузке железом. Чтобы предотвратить или замедлить развитие гемохроматоза, следует удалять избыточное железо, применяядисферал
Лечение • Лечение серповидно-клеточной анемии симптоматическое - эффективных средств, подавляющих образование серповидных клеток in vivo, нет. • Гемотрансфузии могут привести к перегрузке железом. Чтобы предотвратить или замедлить развитие гемохроматоза, следует удалять избыточное железо, применяядисферал
 Иммунные гемолитические анемии – это группа заболеваний, при которых эритроциты крови или эритрокариоциты костного мозга разрушаются антителами, образовавшимися в организме или поступившими извне. Иммунные ГА делятся на 4 группы. • Изоиммунные ГА: • а) гемолитическая анемия плода и новорожденного – заболевание, связанное с антигенной несовместимостью эритроцитов матери и плода чаще по резус-фактору и группе крови; • б)посттранфузионные ГА, связанные с переливанием несовместимых эритроцитов донора, которые разрушаются имеющимися у реципиента атителами.
Иммунные гемолитические анемии – это группа заболеваний, при которых эритроциты крови или эритрокариоциты костного мозга разрушаются антителами, образовавшимися в организме или поступившими извне. Иммунные ГА делятся на 4 группы. • Изоиммунные ГА: • а) гемолитическая анемия плода и новорожденного – заболевание, связанное с антигенной несовместимостью эритроцитов матери и плода чаще по резус-фактору и группе крови; • б)посттранфузионные ГА, связанные с переливанием несовместимых эритроцитов донора, которые разрушаются имеющимися у реципиента атителами.
 2. Трансиммунные ГА – связаны с разрушением эритроцитов плода антителами, поступающими через плаценту от матери, страдающей аутоиммунной ГА, в кровь плода, имеющего те же антигены, что и у матери. 3. Гетероиммунные ГА – обусловленные выработкой антител к чужеродным антигенам: a) при фиксировании лекарств (ПАСК, феноцетин, пенициллин) на поверхности собственных неизмененных эритроцитов; b) при фиксировании вирусов на поверхности собственных неизмененных эритроцитов; c) при изменении антигенной структуры собственных эритроцитов под воздействием лекарств, вирусных инфекций и других факторов. 4. Аутоиммунные ГА – обусловленные выработкой антител к собственным неизмененным антигенам эритроидных клеток.
2. Трансиммунные ГА – связаны с разрушением эритроцитов плода антителами, поступающими через плаценту от матери, страдающей аутоиммунной ГА, в кровь плода, имеющего те же антигены, что и у матери. 3. Гетероиммунные ГА – обусловленные выработкой антител к чужеродным антигенам: a) при фиксировании лекарств (ПАСК, феноцетин, пенициллин) на поверхности собственных неизмененных эритроцитов; b) при фиксировании вирусов на поверхности собственных неизмененных эритроцитов; c) при изменении антигенной структуры собственных эритроцитов под воздействием лекарств, вирусных инфекций и других факторов. 4. Аутоиммунные ГА – обусловленные выработкой антител к собственным неизмененным антигенам эритроидных клеток.
 Аутоиммунные гемолитические анемии Аутоиммунные ГА – это анемии, обусловленные образованием ауто АТ, направленных против поверхностных А аутологичных эритроцитов. Распространенность аутоиммунных - 1: 500000 населения.
Аутоиммунные гемолитические анемии Аутоиммунные ГА – это анемии, обусловленные образованием ауто АТ, направленных против поверхностных А аутологичных эритроцитов. Распространенность аутоиммунных - 1: 500000 населения.
 Аутоиммунные гемолитические анемии (АИГА) подразделяются: A. По принципу клеточной направленности: Ø АИГА с антителами к антигенам эритрокариоцитов костного мозга; Ø АИГА с антителами к антигенам эритроцитов периферической крови; B. По принципу связи с другими заболеваниями: Ø идиопатические АИГА; Ø симптоматические АИГА – при острыхи хронических лимфолейкозах, миеломной болезни, лимфогранулематозе, тимоме, системной красной волчанке, хроническом гепатите, неспецифическом язвенном колите, инфекционном мононуклеозе и пр.
Аутоиммунные гемолитические анемии (АИГА) подразделяются: A. По принципу клеточной направленности: Ø АИГА с антителами к антигенам эритрокариоцитов костного мозга; Ø АИГА с антителами к антигенам эритроцитов периферической крови; B. По принципу связи с другими заболеваниями: Ø идиопатические АИГА; Ø симптоматические АИГА – при острыхи хронических лимфолейкозах, миеломной болезни, лимфогранулематозе, тимоме, системной красной волчанке, хроническом гепатите, неспецифическом язвенном колите, инфекционном мононуклеозе и пр.
 C. По серологическому принципу: Ø АИГА, связанные с неполными тепловыми агглютининами; Ø АИГА, связанные с тепловыми геиолизинами; Ø АИГА, связанные с полными холодовыми агглютининами; Ø АИГА, связанные с двухфазными холодовыми агглютининами.
C. По серологическому принципу: Ø АИГА, связанные с неполными тепловыми агглютининами; Ø АИГА, связанные с тепловыми геиолизинами; Ø АИГА, связанные с полными холодовыми агглютининами; Ø АИГА, связанные с двухфазными холодовыми агглютининами.
 Диагноз АИГА основывается на выявлении аутоантител при проведении пробы Кумбса. При помощи прямой пробы Кумбса определяют антитела, фиксированные на эритроцитах – антиглобулиновые антитела вступают во взаимодействие с иммуноглобулинами эритроцитов и вызывают их агглютинацию. Положительная прямая проба Кумбса отмечается у большинства больных АИГА, ее выраженность тесно коррелирует с количеством Ig. G, фиксированного на эритроцитах.
Диагноз АИГА основывается на выявлении аутоантител при проведении пробы Кумбса. При помощи прямой пробы Кумбса определяют антитела, фиксированные на эритроцитах – антиглобулиновые антитела вступают во взаимодействие с иммуноглобулинами эритроцитов и вызывают их агглютинацию. Положительная прямая проба Кумбса отмечается у большинства больных АИГА, ее выраженность тесно коррелирует с количеством Ig. G, фиксированного на эритроцитах.
 Отрицательная проба Кумбса не исключает диагноз АИГА и может быть следствием недостаточного количества антител (менее 500 молекул Ig. G на эритроците) при нетяжелом хроническом течении заболевания, при обострении, когда после гемолитического криза многие эритроциты разрушены, при гормональной терапии. Кроме того, недостаточное отмывание эритроцитов при выполнении пробы приводит к тому, что на поверхности эритроцитов остаются сывороточные иммуноглобулины, нейтролизующие антиглобулиновую сыворотку; часть антител с поверхности эритроцитов может теряться в процессе отмывания.
Отрицательная проба Кумбса не исключает диагноз АИГА и может быть следствием недостаточного количества антител (менее 500 молекул Ig. G на эритроците) при нетяжелом хроническом течении заболевания, при обострении, когда после гемолитического криза многие эритроциты разрушены, при гормональной терапии. Кроме того, недостаточное отмывание эритроцитов при выполнении пробы приводит к тому, что на поверхности эритроцитов остаются сывороточные иммуноглобулины, нейтролизующие антиглобулиновую сыворотку; часть антител с поверхности эритроцитов может теряться в процессе отмывания.
 Непрямая проба Кумбса, выявляет антиэритроцитарные антитела, циркулирующие в сыворотке крови, не имеет большого значения для диагностики АИГА. Она положительна у большинства лиц, которым длительно применялись гемотрансфузии. Более чувствительной является агрегатгемагглютинационная проба. Ее чувствительность выше чувствительности пробы Кумбса в 100 раз. Значительно более чувствительный антиглобулиновый вариант агрегатгемагглютинационной пробы – в 1000 раз превышает чувствительность пробы Кумбса. Однако, из-за трудоемкости эти методы редко применяются в клинической практике.
Непрямая проба Кумбса, выявляет антиэритроцитарные антитела, циркулирующие в сыворотке крови, не имеет большого значения для диагностики АИГА. Она положительна у большинства лиц, которым длительно применялись гемотрансфузии. Более чувствительной является агрегатгемагглютинационная проба. Ее чувствительность выше чувствительности пробы Кумбса в 100 раз. Значительно более чувствительный антиглобулиновый вариант агрегатгемагглютинационной пробы – в 1000 раз превышает чувствительность пробы Кумбса. Однако, из-за трудоемкости эти методы редко применяются в клинической практике.
 При гемолизиновой форме АИГА сыворотка крови больного вызывает гемолиз эритроцитов донора, в крови обнаруживаются гемолизины, имеются признаки внутрисосудистого гемолиза.
При гемолизиновой форме АИГА сыворотка крови больного вызывает гемолиз эритроцитов донора, в крови обнаруживаются гемолизины, имеются признаки внутрисосудистого гемолиза.
 Лабораторные данные и инструментальные исследования • Общий анализ крови – снижение Hb до 50 – 70 г/л ( при кризах ниже 50 г/л), нормохромия, ретикулоцитоз, СОЭ ускорена. • Общий анализ мочи – уробилинурия. • Общий анализ кала – темного цвета в связи с высоким содержанием. стеркобилина.
Лабораторные данные и инструментальные исследования • Общий анализ крови – снижение Hb до 50 – 70 г/л ( при кризах ниже 50 г/л), нормохромия, ретикулоцитоз, СОЭ ускорена. • Общий анализ мочи – уробилинурия. • Общий анализ кала – темного цвета в связи с высоким содержанием. стеркобилина.
 • Биохимический анализ крови – повышен неконъюгированный билирубин, диспротеинемия (альбумин – снижен, ɤ глобулин повышен), тимоловая проба и сывороточное железо повышены. • Иммунологический анализ крови – снижение количества Т – лимфоцитов – супрессоров, снижение количества иммуноглобулинов, положительная прямая проба Кумбса • Миелограмма – гиперплазия красного ростка кроветворения • УЗИ ОБП – печень и селезенка увеличены
• Биохимический анализ крови – повышен неконъюгированный билирубин, диспротеинемия (альбумин – снижен, ɤ глобулин повышен), тимоловая проба и сывороточное железо повышены. • Иммунологический анализ крови – снижение количества Т – лимфоцитов – супрессоров, снижение количества иммуноглобулинов, положительная прямая проба Кумбса • Миелограмма – гиперплазия красного ростка кроветворения • УЗИ ОБП – печень и селезенка увеличены
 Анализ периферической крови при аутоиммунная гемолитической анемии (АИГА) RBC 2. 12 x 1012/л Hb 82 г/л MCV 121. 7 fl MCH 38. 7 пг MCHC 318 г/л RDW 17. 7 % смешанный выраженный анизоцитоз эритроцитов, сфероцитоз
Анализ периферической крови при аутоиммунная гемолитической анемии (АИГА) RBC 2. 12 x 1012/л Hb 82 г/л MCV 121. 7 fl MCH 38. 7 пг MCHC 318 г/л RDW 17. 7 % смешанный выраженный анизоцитоз эритроцитов, сфероцитоз
 Лечение • Глюкокортикоидная терапия – преднизолон 1 мг/кг массы тела (суточная доза может быть увеличена до 150 мг и даже более). • Распределение суточной дозы 3: 2: 1. • При достижении терапевтического эффекта дозу преднизолона постепенно снижают по 2, 5 мг каждые 4 – 5 дней с последующей отменой.
Лечение • Глюкокортикоидная терапия – преднизолон 1 мг/кг массы тела (суточная доза может быть увеличена до 150 мг и даже более). • Распределение суточной дозы 3: 2: 1. • При достижении терапевтического эффекта дозу преднизолона постепенно снижают по 2, 5 мг каждые 4 – 5 дней с последующей отменой.
 • При хронической АИГА, связанной с неполными тепловыми агглютининами преднизолон применяют в суточной дозе 20 – 30 мг с постепенным переходом на поддерживающую терапию в дозе 5 – 10 мг. • При пароксизмальной холодовой гемоглобинурии лечение состоит в строгом исключении всяких холодовых воздействий. Спленэктомия не показана. Применение иммунодепрессивной терапии ограничено тяжелыми случаями.
• При хронической АИГА, связанной с неполными тепловыми агглютининами преднизолон применяют в суточной дозе 20 – 30 мг с постепенным переходом на поддерживающую терапию в дозе 5 – 10 мг. • При пароксизмальной холодовой гемоглобинурии лечение состоит в строгом исключении всяких холодовых воздействий. Спленэктомия не показана. Применение иммунодепрессивной терапии ограничено тяжелыми случаями.
 • Спленэктомия – рекомендована при неэффективности терапии преднизолоном. Эффективна у 60% больных.
• Спленэктомия – рекомендована при неэффективности терапии преднизолоном. Эффективна у 60% больных.
 • Лечение цитостатиками назначается при неэффективности глюкокортикоидов и спленэктомии - азатиоприн – 100 или 150 мг/сутки, или - винкристин - по 2 мг 1 раз в неделю, или - циклофосфамид - 400 мг через день Лечим до уменьшения гемолиза, чаще вместе с преднизолоном, с переходом на поддерживающую терапию (1/2 первоначальной дозы). Курс лечения может продолжаться до 2 – 3 месяцев!!!
• Лечение цитостатиками назначается при неэффективности глюкокортикоидов и спленэктомии - азатиоприн – 100 или 150 мг/сутки, или - винкристин - по 2 мг 1 раз в неделю, или - циклофосфамид - 400 мг через день Лечим до уменьшения гемолиза, чаще вместе с преднизолоном, с переходом на поддерживающую терапию (1/2 первоначальной дозы). Курс лечения может продолжаться до 2 – 3 месяцев!!!
 • Переливание эритроцитарной массы только при тяжелом гемолитическом кризе или же быстром падении Hb до 30 – 40 г/л (переливаются отмытые эритроциты подобранные с помощью непрямой пробы Кумбса. • Плазмаферез – применяют при развитии ДВС – синдрома и при отсутствии эффекта лечения глюкокортикоидами и циммунодепрессантами.
• Переливание эритроцитарной массы только при тяжелом гемолитическом кризе или же быстром падении Hb до 30 – 40 г/л (переливаются отмытые эритроциты подобранные с помощью непрямой пробы Кумбса. • Плазмаферез – применяют при развитии ДВС – синдрома и при отсутствии эффекта лечения глюкокортикоидами и циммунодепрессантами.
 Пароксизмальноя ночная гемоглобинурия (болезнь Маркиафавы-Микели)
Пароксизмальноя ночная гемоглобинурия (болезнь Маркиафавы-Микели)

 • Т. о. в организме пациента с пароксизмальной ночной гемоглобинурией присутствуют две популяции эритроцитов: одна – нормальная, другая – патологическая, которая появляется в результате соматической мутации и имеет дефект мембраны эритроцитов: – ↓ ацетилхолинэстеразы – ↑ пероксида водорода Эти эритроциты легко разрушаются в присутствии комплемента.
• Т. о. в организме пациента с пароксизмальной ночной гемоглобинурией присутствуют две популяции эритроцитов: одна – нормальная, другая – патологическая, которая появляется в результате соматической мутации и имеет дефект мембраны эритроцитов: – ↓ ацетилхолинэстеразы – ↑ пероксида водорода Эти эритроциты легко разрушаются в присутствии комплемента.
 Для пароксизмальной ночной гемоглобинурии характерны изменения в органах кроветворения: вначале отмечается гиперплазия красного и, нередко, мегакариоцитарного ростков, по мере прогрессирование болезни кроветворная активность костного мозга снижается, могут возникать арегенераторные кризы, в конечной стадии заболевания развивается выраженная диффузная гипоплазия костного мозга.
Для пароксизмальной ночной гемоглобинурии характерны изменения в органах кроветворения: вначале отмечается гиперплазия красного и, нередко, мегакариоцитарного ростков, по мере прогрессирование болезни кроветворная активность костного мозга снижается, могут возникать арегенераторные кризы, в конечной стадии заболевания развивается выраженная диффузная гипоплазия костного мозга.
 Лабораторные признаки пароксизмальной ночной гемоглобинурии 1. Анемический синдром обычно выражен незначительно. В период обострения содержание Hb может снижаться до 30 -50 г/л. 2. В начале анемия носит нормохромный характер, но при длительной гемоглобиноурии и гемосидеринурии развивается железодефицитное состояние и анемия становится гипохомной. 3. В мазке крови отмечается анизоцитоз со склонностью к макроцитозу, реже анемия носит нормоцитарный характер; пойкилоцитоз; в начеле заболевания эритроциты нормохромные, по мере его развития нарастает их гипохромия; полихроматофилия, могут встречаться нормобласты.
Лабораторные признаки пароксизмальной ночной гемоглобинурии 1. Анемический синдром обычно выражен незначительно. В период обострения содержание Hb может снижаться до 30 -50 г/л. 2. В начале анемия носит нормохромный характер, но при длительной гемоглобиноурии и гемосидеринурии развивается железодефицитное состояние и анемия становится гипохомной. 3. В мазке крови отмечается анизоцитоз со склонностью к макроцитозу, реже анемия носит нормоцитарный характер; пойкилоцитоз; в начеле заболевания эритроциты нормохромные, по мере его развития нарастает их гипохромия; полихроматофилия, могут встречаться нормобласты.
 4. Ретикулоцитоз равнительно небольшой – 20 -40‰ (2 -4%), не соответствующий степени анемии. В период арегенераторных кризов отмечается ретикулоцитопения. 5. Выявляется почти постоянная лейкопения с нейтропенией, относительный лимфоцитоз, периодически наблюдается моноцитоз, эозинофилия, базофилия. 6. Тромбоцитопения от небольшой до значительной (ниже 30 г/л). 7. Биохимические показатели: - в период криза в сыворотке повышен уровень непрямого билирубина, выявляется свободный гемоглобин, снижено содержание гаптоглобина; - в моче выявляется гемоглобин, гемосидерин.
4. Ретикулоцитоз равнительно небольшой – 20 -40‰ (2 -4%), не соответствующий степени анемии. В период арегенераторных кризов отмечается ретикулоцитопения. 5. Выявляется почти постоянная лейкопения с нейтропенией, относительный лимфоцитоз, периодически наблюдается моноцитоз, эозинофилия, базофилия. 6. Тромбоцитопения от небольшой до значительной (ниже 30 г/л). 7. Биохимические показатели: - в период криза в сыворотке повышен уровень непрямого билирубина, выявляется свободный гемоглобин, снижено содержание гаптоглобина; - в моче выявляется гемоглобин, гемосидерин.
 Специальные методы исследования a) Положительный кислотный тест (проба Хема) – эритроциты больного в свежей подкисленной человеческой сыворотке подвергаются гемолизу, нормальные эритроциты – нет. b) Положительная сахарозная проба (тест Хартмана) – при добавлении сахарозы к одногрупной донорской сыворотке эритроциты больного быстро гемолизируются, нормальные эритроциты – нет.
Специальные методы исследования a) Положительный кислотный тест (проба Хема) – эритроциты больного в свежей подкисленной человеческой сыворотке подвергаются гемолизу, нормальные эритроциты – нет. b) Положительная сахарозная проба (тест Хартмана) – при добавлении сахарозы к одногрупной донорской сыворотке эритроциты больного быстро гемолизируются, нормальные эритроциты – нет.
 Костный мозг вначале заболевания геперклеточный за счет увеличения количества эритроидных клеток, нередко повышено число мегакариоцитов. При прогрессировании заболевания уменьшается количество эритркари- оцитов, мегакариоцитов, элементов лейкопоэза, отмечается задержка их созревания на стадии миелоцита. В конечной стадии выявляется панцитопения.
Костный мозг вначале заболевания геперклеточный за счет увеличения количества эритроидных клеток, нередко повышено число мегакариоцитов. При прогрессировании заболевания уменьшается количество эритркари- оцитов, мегакариоцитов, элементов лейкопоэза, отмечается задержка их созревания на стадии миелоцита. В конечной стадии выявляется панцитопения.
 Лечение • Патогенетического лечения не существует!!! 1. Переливание эритроцитов – при тяжелом общем состоянии пациента и низком уровне Hb (переливают отмытые эритроциты). 2. Лечение анаболическими препаратами - обладают антикомплиментарным действием - анаполол (150 – 200 мг/сут на протяжении 2 – 3 месяцев) 3. Лечение антиоксидантами - токоферола ацетат (100 мг по 2 капсулы в день на протяжении 1 -3 месяцев
Лечение • Патогенетического лечения не существует!!! 1. Переливание эритроцитов – при тяжелом общем состоянии пациента и низком уровне Hb (переливают отмытые эритроциты). 2. Лечение анаболическими препаратами - обладают антикомплиментарным действием - анаполол (150 – 200 мг/сут на протяжении 2 – 3 месяцев) 3. Лечение антиоксидантами - токоферола ацетат (100 мг по 2 капсулы в день на протяжении 1 -3 месяцев
 Гемолитические анемии, связанные с механическим повреждением эритроцитов Гемолитические связанные анемии, с механическим повреждением эритроцитов – могут развиваться при протезировании сосудов или клапанов сердца, стенозе аортального клапана, злокачественной гипертензии, ДВС-синдроме, гемолитико-уремическом синдроме, гемангиомах, длительной ходьбе с грузом (маршевая гемоглобинурия).
Гемолитические анемии, связанные с механическим повреждением эритроцитов Гемолитические связанные анемии, с механическим повреждением эритроцитов – могут развиваться при протезировании сосудов или клапанов сердца, стенозе аортального клапана, злокачественной гипертензии, ДВС-синдроме, гемолитико-уремическом синдроме, гемангиомах, длительной ходьбе с грузом (маршевая гемоглобинурия).
Механический гемолиз Шлемовидные эритроциты
Механический гемолиз Шлемовидные эритроциты
 Дифференциальная диагностика анемий Показатель ГА ЖДА В 12 -дефицит ная анемия Гипопластич ская анемия Цветовой Норма показатель Снижен Повышен Норма Ретикулоци Значительно ты Повышены М. б умеренно повышены Снижено Железо сыворотки Норма или Повышено Снижено Норма или Умеренно повышено Норма или повышено Непрямой билирубин Повышен Норма М. б умеренно повышено Норма Костный мозг Гиперплазия М. б умерен- Мегалобласт эритроцитарн ная гиперное кроветвоого ростка плазия рение эритроцитар ного ростка Гипоплазия костного мозга
Дифференциальная диагностика анемий Показатель ГА ЖДА В 12 -дефицит ная анемия Гипопластич ская анемия Цветовой Норма показатель Снижен Повышен Норма Ретикулоци Значительно ты Повышены М. б умеренно повышены Снижено Железо сыворотки Норма или Повышено Снижено Норма или Умеренно повышено Норма или повышено Непрямой билирубин Повышен Норма М. б умеренно повышено Норма Костный мозг Гиперплазия М. б умерен- Мегалобласт эритроцитарн ная гиперное кроветвоого ростка плазия рение эритроцитар ного ростка Гипоплазия костного мозга


